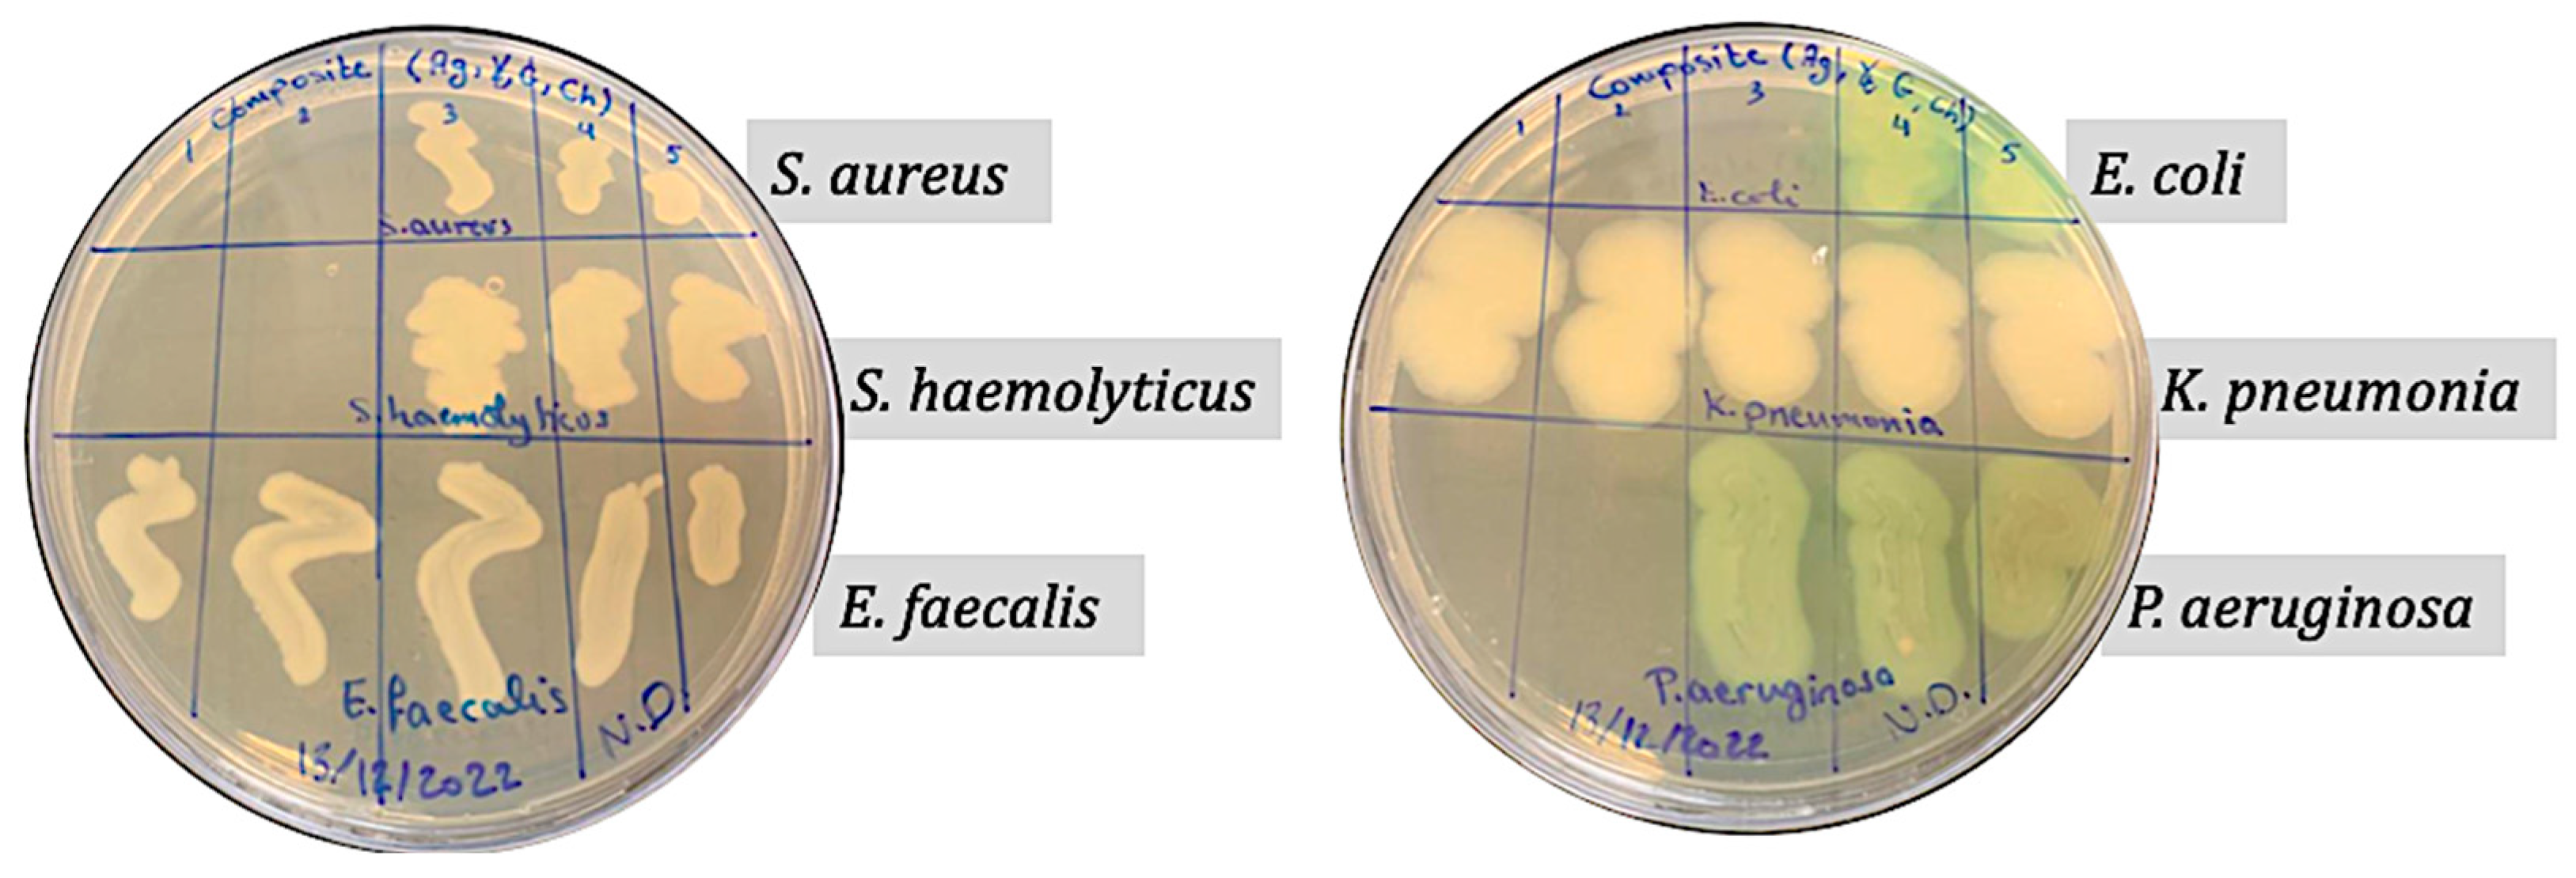
Processes 12 02590 g009
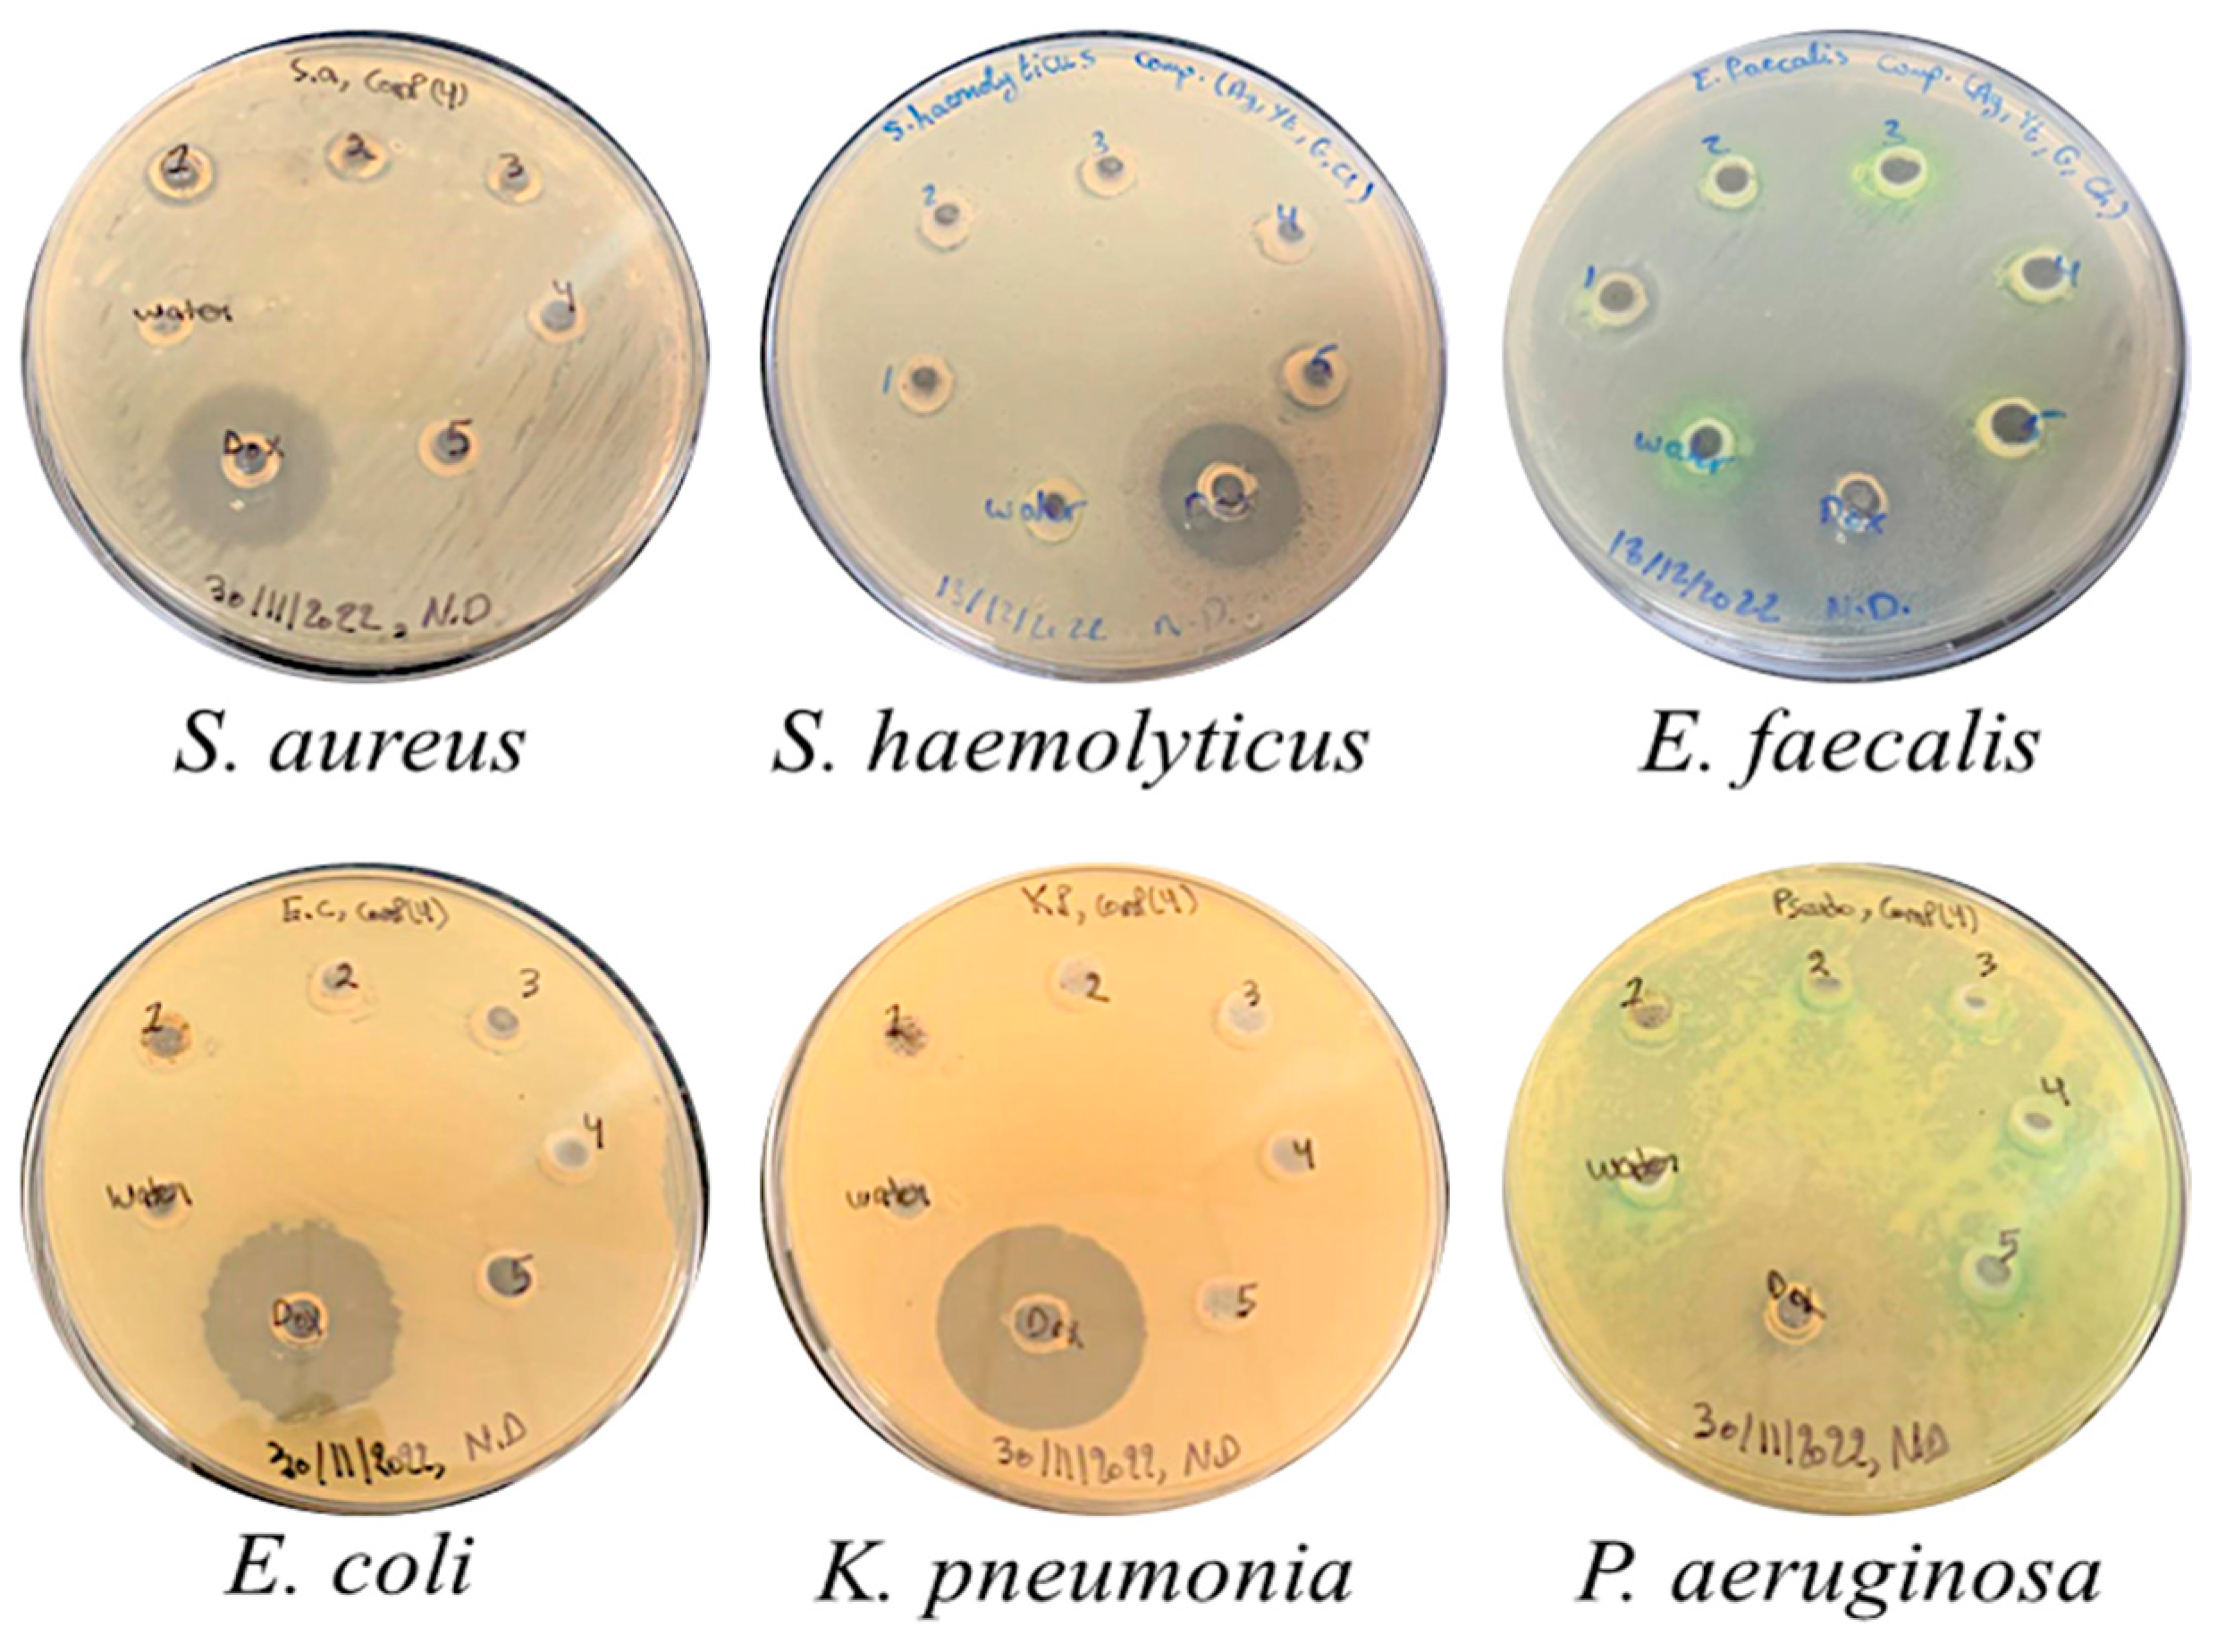
Processes 12 02590 g010

Biosynthesis; Characterization; and Antibacterial, Antioxidant, and Docking Potentials of Doped Silver Nanoparticles Synthesized from Pine Needle Leaf Extract
Abstract
1. Introduction
2. Materials and Methods
2.1. Pine Needle Collection and Extract Preparation
2.2. Biosynthesis of the Doped AgNPs
2.3. Characterization Techniques
2.3.1. X-Ray Diffraction (XRD)
2.3.2. Transmission Electron Microscopy (TEM)
2.3.3. X-Ray Photoelectron Spectroscopy (XPS)
2.3.4. Scanning Electron Microscopy (SEM) and Energy-Dispersive X-Ray (EDX)
2.3.5. Fourier Transform Infrared Spectroscopy (FTIR)
2.3.6. UV–Visible Spectroscopy (UV–Vis)
2.3.7. Photoluminescence (PL)
2.3.8. Vibrating Sample Magnetometry (VSM)
2.4. Antibacterial Activity of the Doped AgNPs
2.4.1. Preparation of Bacterial Suspensions
2.4.2. Broth Microdilution Assay for Detecting the Minimum Inhibitory Concentrations (MICs) and Minimum Bactericidal Concentrations (MBCs) of the Doped AgNPs
2.4.3. Agar Well Diffusion for Detecting the Zones of Inhibition (ZOIs) of the Doped AgNPs
2.4.4. Time–Kill Test for Detecting the Time Needed by the Doped AgNPs to Inhibit Bacterial Growth
2.4.5. Anti-Biofilm Assay for the Detection of the Ability of the Doped AgNPs to Inhibit the Formation of Biofilms and Eradicate Pre-Formed Biofilms
2.5. 1,1, Diphenyl 1-2 Picrylhydrazyl (DPPH) Free Radical Scavenging Assay for Detecting the Antioxidant Activity of the Doped AgNPs
2.6. Molecular Docking Simulation
2.7. Statistical Analysis
3. Results and Discussion
3.1. Characterization of the Doped AgNPs
3.1.1. X-Ray Diffraction (XRD)
3.1.2. Transmission Electron Microscopic (TEM) Analysis
3.1.3. X-Ray Photoelectron Spectroscopy (XPS)
3.1.4. Scanning Electron Microscopy (SEM) with Energy-Dispersive X-Ray (EDX) Spectroscopy Analysis
3.1.5. Fourier Transform Infrared (FTIR) Analysis
3.1.6. Visual Observation and UV–Vis Spectroscopy Analysis
3.1.7. Photoluminescence (PL) Studies
3.1.8. Vibrating Sample Magnetometer (VSM)
3.2. Antibacterial Activity of the Doped AgNPs Against Uro-Pathogenic Bacteria
3.2.1. Minimum Inhibitory Concentrations (MICs) and Minimum Bactericidal Concentrations (MBCs) of the Doped AgNPs
3.2.2. Inhibition of Bacterial Growth Induced by the Doped AgNPs Shown by the Zones of Inhibition (ZOIs) Through Agar Well Diffusion
3.2.3. Time–Kill Results of the Doped AgNPs Against Bacterial Isolates
3.2.4. Inhibition of Biofilm Formation and Eradication of Pre-Formed Biofilms by the Doped AgNPs
Inhibition of Bacterial Biofilm Formation by the Doped AgNPs
Destruction of Pre-Formed Bacterial Biofilms by the Undoped and Doped AgNPs
3.3. Antioxidant Activity of the Doped AgNPs Against DPPH by Radical Scavenging Assay
3.4. Molecular Docking of Doped AgNPs with Antibacterial Target Proteins
4. Conclusions
Supplementary Materials
Author Contributions
Funding
Data Availability Statement
Conflicts of Interest
References
- Micoli, F.; Bagnoli, F.; Rappuoli, R.; Serruto, D. The role of vaccines in combatting antimicrobial resistance. Nat. Rev. Microbiol. 2021, 19, 287–302. [Google Scholar] [CrossRef] [PubMed]
- Liguori, K.; Keenum, I.; Davis, B.C.; Calarco, J.; Milligan, E.; Harwood, V.J.; Pruden, A. Antimicrobial Resistance Monitoring of Water Environments: A Framework for Standardized Methods and Quality Control. Environ. Sci. Technol. 2022, 56, 9149–9160. [Google Scholar] [CrossRef] [PubMed]
- Fernandes, M.; González-Ballesteros, N.; Da Costa, A.; Machado, R.; Gomes, A.C.; Rodríguez-Argüelles, M.C. Antimicrobial and anti-biofilm activity of silver nanoparticles biosynthesized with Cystoseira algae extracts. JBIC J. Biol. Inorg. Chem. 2023, 28, 439–450. [Google Scholar] [CrossRef] [PubMed]
- Ndeh, D.; Rogowski, A.; Cartmell, A.; Luis, A.S.; Baslé, A.; Gray, J.; Venditto, I.; Briggs, J.; Zhang, X.; Labourel, A.; et al. Complex pectin metabolism by gut bacteria reveals novel catalytic functions. Nature 2017, 544, 65–70. [Google Scholar] [CrossRef] [PubMed]
- Rajendran, R.; Mani, A. Photocatalytic, antibacterial and anticancer activity of silver-doped zinc oxide nanoparticles. J. Saudi Chem. Soc. 2020, 24, 1010–1024. [Google Scholar] [CrossRef]
- Salem, S.S.; EL-Belely, E.F.; Niedbała, G.; Alnoman, M.M.; Hassan, S.E.-D.; Eid, A.M.; Shaheen, T.I.; Elkelish, A.; Fouda, A. Bactericidal and In-Vitro Cytotoxic Efficacy of Silver Nanoparticles (Ag-NPs) Fabricated by Endophytic Actinomycetes and Their Use as Coating for the Textile Fabrics. Nanomaterials 2020, 10, 2082. [Google Scholar] [CrossRef]
- Shehabeldine, A.M.; Amin, B.H.; Hagras, F.A.; Ramadan, A.A.; Kamel, M.R.; Ahmed, M.A.; Atia, K.H.; Salem, S.S. Potential Antimicrobial and Antibiofilm Properties of Copper Oxide Nanoparticles: Time-Kill Kinetic Essay and Ultrastructure of Pathogenic Bacterial Cells. Appl. Biochem. Biotechnol. 2023, 195, 467–485. [Google Scholar] [CrossRef]
- Roy, A.; Srinivas, V.; Ram, S.; Rao, T.V.C. The effect of silver coating on magnetic properties of oxygen-stabilized tetragonal Ni nanoparticles prepared by chemical reduction. J. Phys. Condens. Matter 2007, 19, 346220. [Google Scholar] [CrossRef]
- Tariq, M.; Mohammad, K.N.; Ahmed, B.; Siddiqui, M.A.; Lee, J. Biological Synthesis of Silver Nanoparticles and Prospects in Plant Disease Management. Molecules 2022, 27, 4754. [Google Scholar] [CrossRef]
- Akter, M.; Sikder, M.T.; Rahman, M.M.; Ullah, A.K.M.A.; Hossain, K.F.B.; Banik, S.; Hosokawa, T.; Saito, T.; Kurasaki, M. A systematic review on silver nanoparticles-induced cytotoxicity: Physicochemical properties and perspectives. J. Adv. Res. 2018, 9, 1–16. [Google Scholar] [CrossRef]
- Singh, G.; Katoch, M. Antimicrobial activities and mechanism of action of Cymbopogon khasianus (Munro ex Hackel) Bor essential oil. BMC Complement. Med. Ther. 2020, 20, 331. [Google Scholar] [CrossRef] [PubMed]
- Breznica, P.; Koliqi, R.; Daka, A. A review of the current understanding of nanoparticles protein corona composition. Med. Pharm. Rep. 2020, 93, 342–350. [Google Scholar] [CrossRef] [PubMed]
- Kapoor, R.T.; Salvadori, M.R.; Rafatullah, M.; Siddiqui, M.R.; Khan, M.A.; Alshareef, S.A. Exploration of Microbial Factories for Synthesis of Nanoparticles—A Sustainable Approach for Bioremediation of Environmental Contaminants. Front. Microbiol. 2021, 12, 658294. [Google Scholar] [CrossRef] [PubMed]
- Singh, P.; Pandit, S.; Jers, C.; Joshi, A.S.; Garnæs, J.; Mijakovic, I. Silver nanoparticles produced from Cedecea sp. exhibit antibiofilm activity and remarkable stability. Sci. Rep. 2021, 11, 12619. [Google Scholar] [CrossRef]
- Singh, P.; Pandit, S.; Garnæs, J.; Tunjic, S.; Mokkapati, V.; Sultan, A.; Thygesen, A.; Mackevica, A.; Mateiu, R.V.; Daugaard, A.E.; et al. Green synthesis of gold and silver nanoparticles from Cannabis sativa (industrial hemp) and their capacity for biofilm inhibition. Int. J. Nanomed. 2018, 13, 3571–3591. [Google Scholar] [CrossRef]
- Shenoy, R.U.K.; Rama, A.; Govindan, I.; Naha, A. The purview of doped nanoparticles: Insights into their biomedical applications. OpenNano 2022, 8, 100070. [Google Scholar] [CrossRef]
- Darwich, N.A.; Mezher, M.; Abdallah, A.M.; El-Sayed, A.F.; El Hajj, R.; Hamdalla, T.A.; Khalil, M.I. Green Synthesis of Yttrium Derivatives Nanoparticles Using Pine Needle Leaf Extract: Characterization, Docking, Antibacterial, and Antioxidant Potencies. Processes 2024, 12, 1713. [Google Scholar] [CrossRef]
- Blomqvist, L.; Nordberg, G.F.; Nurchi, V.M.; Aaseth, J.O. Gadolinium in Medical Imaging—Usefulness, Toxic Reactions and Possible Countermeasures—A Review. Biomolecules 2022, 12, 742. [Google Scholar] [CrossRef]
- Khan, S.A.; Shahid, S.; Hanif, S.; Almoallim, H.S.; Alharbi, S.A.; Sellami, H. Green Synthesis of Chromium Oxide Nanoparticles for Antibacterial, Antioxidant Anticancer, and Biocompatibility Activities. Int. J. Mol. Sci. 2021, 22, 502. [Google Scholar] [CrossRef]
- Gyawali, N.; Kandel, R.; Lee, I.; Shrestha, S.; Pandey, A.; Akter, J.; Ryang, J. Silver decoration of Cr2O3 nanoparticles: Facile preparation of Cr2O3 nanoparticles and Ag–Cr2O3 nanocomposites and characterization of their antibacterial activity and ability to photocatalytically degrade organic wastes under visible light. J. Photochem. Photobiol. A Chem. 2024, 47, 115251. [Google Scholar] [CrossRef]
- Prabitha, V.G.; Sahadevan, J.; Madhavan, M.; Muthu, S.E.; Kim, I.; Sudheer, T.K.; Sivaprakash, P. Effect of Yttrium doping on antibacterial and antioxidant property of LaTiO3. Discov. Nano 2023, 18, 155. [Google Scholar] [CrossRef] [PubMed]
- Aashima; Pandey, S.K.; Singh, S.; Mehta, S.K. Biocompatible gadolinium oxide nanoparticles as efficient agent against pathogenic bacteria. J. Colloid Interface Sci. 2018, 529, 496–504. [Google Scholar] [CrossRef] [PubMed]
- Mezher, M.; Hajj, R.E.; Khalil, M. Investigating the antimicrobial activity of essential oils against pathogens isolated from sewage sludge of southern Lebanese villages. GERMS 2022, 12, 488–506. [Google Scholar] [CrossRef]
- Adnan, R.; Abdallah, A.M.; Mezher, M.; Noun, M.; Khalil, M.; Awad, R. Impact of Mg-doping on the structural, optical, and magnetic properties of CuO nanoparticles and their antibiofilm activity. Phys. Scr. 2023, 98, 055935. [Google Scholar] [CrossRef]
- Adnan, R.M.; Mezher, M.; Abdallah, A.M.; Awad, R.; Khalil, M.I. Synthesis, Characterization, and Antibacterial Activity of Mg-Doped CuO Nanoparticles. Molecules 2022, 28, 103. [Google Scholar] [CrossRef] [PubMed]
- Rabaa, M.; Mezher, M.; Aridi, A.; Naoufal, D.; Khalil, M.I.; Awad, R.; Abdeen, W. Influence of Lanthanum Doping on the Photocatalytic and Antibacterial Capacities of Mg0.33Ni0.33Co0.33Fe2O4 Nanoparticles. Catalysts 2023, 13, 693. [Google Scholar] [CrossRef]
- Rabaa, M.; Mezher, M.; Aridi, A.; Naoufal, D.; Khalil, M.; Awad, R. Improved Photocatalytic and Antibacterial Activity of Mg0.33Ni0.33Co0.33GdxFe2−xO4 Nanoparticles Synthesized via the Co-precipitation Method. ChemistrySelect 2023, 8, e202301951. [Google Scholar] [CrossRef]
- Baliyan, S.; Mukherjee, R.; Priyadarshini, A.; Vibhuti, A.; Gupta, A.; Pandey, R.P.; Chang, C.-M. Determination of Antioxidants by DPPH Radical Scavenging Activity and Quantitative Phytochemical Analysis of Ficus religiosa. Molecules 2022, 27, 1326. [Google Scholar] [CrossRef]
- Shabnam, N.; Sharmila, P.; Kim, H.; Pardha-Saradhi, P. Light Mediated Generation of Silver Nanoparticles by Spinach Thylakoids/Chloroplasts. PLoS ONE 2016, 11, e0167937. [Google Scholar] [CrossRef]
- Sharifi-Rad, M.; Pohl, P.; Epifano, F.; Álvarez-Suarez, J.M. Green Synthesis of Silver Nanoparticles Using Astragalus tribuloides Delile. Root Extract: Characterization, Antioxidant, Antibacterial, and Anti-Inflammatory Activities. Nanomaterials 2020, 10, 2383. [Google Scholar] [CrossRef]
- Jing, Y.; Lei, Q.; Xia, C.; Guan, Y.; Yang, Y.; He, J.; Yang, Y.; Zhang, Y.; Yan, M. Synthesis of Ag and AgCl co-doped ZIF-8 hybrid photocatalysts with enhanced photocatalytic activity through a synergistic effect. RSC Adv. 2020, 10, 698–704. [Google Scholar] [CrossRef] [PubMed]
- López-Miranda, J.L.; Mares-Briones, F.; Silva, R.; Esparza, R.; Estevez, M. Green synthesis and characterization of metallic nanoparticles with environmental applications. MRS Adv. 2023, 8, 1172–1176. [Google Scholar] [CrossRef]
- Raj, S.; Trivedi, R.; Soni, V. Biogenic Synthesis of Silver Nanoparticles, Characterization and Their Applications—A Review. Surfaces 2021, 5, 67–90. [Google Scholar] [CrossRef]
- Ahmad, F.; Ashraf, N.; Ashraf, T.; Zhou, R.-B.; Yin, D.-C. Biological synthesis of metallic nanoparticles (MNPs) by plants and microbes: Their cellular uptake, biocompatibility, and biomedical applications. Appl. Microbiol. Biotechnol. 2019, 103, 2913–2935. [Google Scholar] [CrossRef] [PubMed]
- Annamalai, N.; Thavasi, R.; Vijayalakshmi, S.; Balasubramanian, T. A novel thermostable and halostable carboxymethylcellulase from marine bacterium Bacillus licheniformisAU01. World J. Microbiol. Biotechnol. 2011, 27, 2111–2115. [Google Scholar] [CrossRef]
- Anandalakshmi, K.; Venugobal, J.; Ramasamy, V. Characterization of silver nanoparticles by green synthesis method using Pedalium murex leaf extract and their antibacterial activity. Appl. Nanosci. 2016, 6, 399–408. [Google Scholar] [CrossRef]
- Al-Bataineh, Q.M.; Ababneh, R.; Bahti, A.; Bani-Salameh, A.A.; Tavares, C.J.; Telfah, A. Effect of hydrogen-related shallow donor on the physical and chemical properties of Ag-doped ZnO nanostructures. J. Mater. Sci. Mater. Electron. 2022, 33, 17434–17445. [Google Scholar] [CrossRef]
- Kanwal, Z.; Raza, M.A.; Riaz, S.; Manzoor, S.; Tayyeb, A.; Sajid, I.; Naseem, S. Synthesis and characterization of silver nanoparticle-decorated cobalt nanocomposites (Co@AgNPs) and their density-dependent antibacterial activity. R. Soc. Open Sci. 2019, 6, 182135. [Google Scholar] [CrossRef]
- Labulo, A.H.; David, O.A.; Terna, A.D. Green synthesis and characterization of silver nanoparticles using Morinda lucida leaf extract and evaluation of its antioxidant and antimicrobial activity. Chem. Pap. 2022, 76, 7313–7325. [Google Scholar] [CrossRef]
- Asif, M.; Yasmin, R.; Asif, R.; Ambreen, A.; Mustafa, M.; Umbreen, S. Green Synthesis of Silver Nanoparticles (AgNPs), Structural Characterization, and their Antibacterial Potential. Dose-Response 2022, 20, 155932582210887. [Google Scholar] [CrossRef]
- Arya, S.K.; Dey, A.; Bhansali, S. Polyaniline protected gold nanoparticles based mediator and label free electrochemical cortisol biosensor. Biosens. Bioelectron. 2011, 28, 166–173. [Google Scholar] [CrossRef] [PubMed]
- Lin, Z.Y.; Xiao, J.; Yan, J.H.; Liu, P.; Li, L.H.; Yang, G.W. Ag/AgCl plasmonic cubes with ultrahigh activity as advanced visible-light photocatalysts for photodegrading dyes. J. Mater. Chem. A 2015, 3, 7649–7658. [Google Scholar] [CrossRef]
- Zhang, Y.; Alagic, Z.; Tani, E.; Skorpil, M.; Tsagkozis, P.; Haglund, F. Clear-cell chondrosarcomas: Fine-needle aspiration cytology, radiological findings, and patient demographics of a rare entity. Diagn. Cytopathol. 2021, 49, 46–53. [Google Scholar] [CrossRef] [PubMed]
- Duc Chinh, V.; Speranza, G.; Migliaresi, C.; Van Chuc, N.; Minh Tan, V.; Phuong, N.-T. Synthesis of Gold Nanoparticles Decorated with Multiwalled Carbon Nanotubes (Au-MWCNTs) via Cysteaminium Chloride Functionalization. Sci. Rep. 2019, 9, 5667. [Google Scholar] [CrossRef]
- Song, J.-B.; Kim, J.-T.; Oh, S.-G.; Yun, J.-Y. Contamination Particles and Plasma Etching Behavior of Atmospheric Plasma Sprayed Y2O3 and YF3 Coatings under NF3 Plasma. Coatings 2019, 9, 102. [Google Scholar] [CrossRef]
- Elemike, E.E.; Onwudiwe, D.C.; Ekennia, A.C.; Jordaan, A. Synthesis and characterisation of silver nanoparticles using leaf extract of Artemisia afra and their in vitro antimicrobial and antioxidant activities. IET Nanobiotechnol. 2018, 12, 722–726. [Google Scholar] [CrossRef]
- Zhang, X.; Yang, C.; Zhou, J.; Huo, M. Somatostatin Receptor-Mediated Tumor-Targeting Nanocarriers Based on Octreotide-PEG Conjugated Nanographene Oxide for Combined Chemo and Photothermal Therapy. Small 2016, 12, 3578–3590. [Google Scholar] [CrossRef]
- Chang, M.; Tie, S. Fabrication of novel luminor Y2O3: Eu3+@SiO2@YVO4:Eu3+ with core/shell heteronanostructure. Nanotechnology 2008, 19, 075711. [Google Scholar] [CrossRef]
- Suriyakala, G.; Sathiyaraj, S.; Devanesan, S.; AlSalhi, M.S.; Rajasekar, A.; Maruthamuthu, M.K.; Babujanarthanam, R. Phytosynthesis of silver nanoparticles from Jatropha integerrima Jacq. flower extract and their possible applications as antibacterial and antioxidant agent. Saudi J. Biol. Sci. 2022, 29, 680–688. [Google Scholar] [CrossRef]
- Hachem, Z.; Kashmar, R.; Abdallah, A.M.; Awad, R.; Khalil, M.I. Characterization, antioxidant, antibacterial, and antibiofilm properties of biosynthesized Ag/AgCl nanoparticles using Origanum ehrenbergii Boiss. Results Mater. 2024, 21, 100550. [Google Scholar] [CrossRef]
- Harshapriya, P.; Basandrai, D.; Kaur, P. Structural and optical properties of Yttrium-Silver doped ZnO nanoparticle. Mater. Today Proc. 2023, 4, S2214785323003267. [Google Scholar] [CrossRef]
- Juluri, M.; Mohammed, R.A.; Mohan, S.; Golla, N.; Krishna, S.B.N.; Battini, K. Green synthesis, characterization and biological activities of silver nanoparticles synthesized from Neolamarkia cadamba. ADMET DMPK 2023, 11, 573–585. [Google Scholar] [CrossRef]
- Coates, J. Interpretation of Infrared Spectra, A Practical Approach. In Encyclopedia of Analytical Chemistry; Meyers, R.A., Ed.; Wiley: Hoboken, NJ, USA, 2000. [Google Scholar] [CrossRef]
- Jagathy, K.; Malathi, S. Characterization and Green Biosynthesis of Silver Nanoparticles using Raphanus sativus and its Antibacterial Activity against Urinary Tract Infection Causing E. coli. Int. J. Curr. Res. Rev. 2021, 13, 40–45. [Google Scholar] [CrossRef]
- Thirunavoukkarasu, M.; Balaji, U.; Behera, S.; Panda, P.K.; Mishra, B.K. Biosynthesis of silver nanoparticle from leaf extract of Desmodium gangeticum (L.) DC. and its biomedical potential. Spectrochim. Acta. A. Mol. Biomol. Spectrosc. 2013, 116, 424–427. [Google Scholar] [CrossRef] [PubMed]
- Aghazadeh, M.; Ghaemi, M.; Nozad Golikand, A.; Yousefi, T.; Jangju, E. Yttrium Oxide Nanoparticles Prepared by Heat Treatment of Cathodically Grown Yttrium Hydroxide. ISRN Ceram. 2011, 2011, 542104. [Google Scholar] [CrossRef]
- Jain, S.; Mehata, M.S. Medicinal Plant Leaf Extract and Pure Flavonoid Mediated Green Synthesis of Silver Nanoparticles and their Enhanced Antibacterial Property. Sci. Rep. 2017, 7, 15867. [Google Scholar] [CrossRef]
- Saranya, D.; Sekar, J. GC-MS and FT-IR Analyses of Ethylacetate Leaf extract of Abutilon indicum (L.) Sweet. Int. J. Adv. Res. Biol. Sci. 2016, 3, 193–197. [Google Scholar]
- Benammar, I.; Salhi, R.; Deschanvres, J.-L.; Maalej, R. The effect of rare earth element (Er, Yb) doping and heat treatment on suspension stability of Y2O3 nanoparticles elaborated by sol-gel method. J. Mater. Res. Technol. 2020, 9, 12634–12642. [Google Scholar] [CrossRef]
- Ali, I.A.M.; Ahmed, A.B.; Al-Ahmed, H.I. Green synthesis and characterization of silver nanoparticles for reducing the damage to sperm parameters in diabetic compared to metformin. Sci. Rep. 2023, 13, 2256. [Google Scholar] [CrossRef]
- Yaqoob, A.A.; Ahmad, H.; Parveen, T.; Ahmad, A.; Oves, M.; Ismail, I.M.I.; Qari, H.A.; Umar, K.; Mohamad Ibrahim, M.N. Recent Advances in Metal Decorated Nanomaterials and Their Various Biological Applications: A Review. Front. Chem. 2020, 8, 341. [Google Scholar] [CrossRef]
- Francis, S.; Joseph, S.; Koshy, E.P.; Mathew, B. Microwave assisted green synthesis of silver nanoparticles using leaf extract of Elephantopus scaber and its environmental and biological applications. Artif. Cells Nanomed. Biotechnol. 2018, 46, 795–804. [Google Scholar] [CrossRef] [PubMed]
- Gong, R.; Chen, G. Preparation and application of functionalized nano drug carriers. Saudi Pharm. J. 2016, 24, 254–257. [Google Scholar] [CrossRef] [PubMed]
- Benedec, D.; Oniga, I.; Cuibus, F.; Sevastre, B.; Stiufiuc, G.; Duma, M.; Hanganu, D.; Iacovita, C.; Stiufiuc, R.; Lucaciu, C.M. Origanum vulgare mediated green synthesis of biocompatible gold nanoparticles simultaneously possessing plasmonic, antioxidant and antimicrobial properties. Int. J. Nanomed. 2018, 13, 1041–1058. [Google Scholar] [CrossRef] [PubMed]
- Radičić, R.; Maletić, D.; Blažeka, D.; Car, J.; Krstulović, N. Synthesis of Silver, Gold, and Platinum Doped Zinc Oxide Nanoparticles by Pulsed Laser Ablation in Water. Nanomaterials 2022, 12, 3484. [Google Scholar] [CrossRef] [PubMed]
- Yamamoto, Y.; Miura, T.; Suzuki, M.; Kawamura, N.; Miyagawa, H.; Nakamura, T.; Kobayashi, K.; Teranishi, T.; Hori, H. Direct Observation of Ferromagnetic Spin Polarization in Gold Nanoparticles. Phys. Rev. Lett. 2004, 93, 116801. [Google Scholar] [CrossRef]
- Amiar Rodin, N.L.; Sahar, M.R.; Mohd-Noor, F. Magnetic analysis of cobalt oxide nanoparticles comprised boro-tellurite glass with erbium lanthanide. J. Magn. Magn. Mater. 2020, 496, 165931. [Google Scholar] [CrossRef]
- Kowalik, P.; Mikulski, J.; Borodziuk, A.; Duda, M.; Kamińska, I.; Zajdel, K.; Rybusinski, J.; Szczytko, J.; Wojciechowski, T.; Sobczak, K.; et al. Yttrium-Doped Iron Oxide Nanoparticles for Magnetic Hyperthermia Applications. J. Phys. Chem. C 2020, 124, 6871–6883. [Google Scholar] [CrossRef]
- Ullah, A.K.M.A.; Kabir, M.F.; Akter, M.; Tamanna, A.N.; Hossain, A.; Tareq, A.R.M.; Khan, M.N.I.; Kibria, A.K.M.F.; Kurasaki, M.; Rahman, M.M. Green synthesis of bio-molecule encapsulated magnetic silver nanoparticles and their antibacterial activity. RSC Adv. 2018, 8, 37176–37183. [Google Scholar] [CrossRef]
- Dagher, L.A.; Hassan, J.; Kharroubi, S.; Jaafar, H.; Kassem, I.I. Nationwide Assessment of Water Quality in Rivers across Lebanon by Quantifying Fecal Indicators Densities and Profiling Antibiotic Resistance of Escherichia coli. Antibiotics 2021, 10, 883. [Google Scholar] [CrossRef]
- Huq, M.A.; Khan, A.A.; Alshehri, J.M.; Rahman, M.S.; Balusamy, S.R.; Akter, S. Bacterial mediated green synthesis of silver nanoparticles and their antibacterial and antifungal activities against drug-resistant pathogens. R. Soc. Open Sci. 2023, 10, 230796. [Google Scholar] [CrossRef]
- Sudarsan, S.; Kumar Shankar, M.; Kumar Belagal Motatis, A.; Shankar, S.; Krishnappa, D.; Mohan, C.D.; Rangappa, K.S.; Gupta, V.K.; Siddaiah, C.N. Green Synthesis of Silver Nanoparticles by Cytobacillus firmus Isolated from the Stem Bark of Terminalia arjuna and Their Antimicrobial Activity. Biomolecules 2021, 11, 259. [Google Scholar] [CrossRef] [PubMed]
- Sayed, F.A.-Z.; Eissa, N.G.; Shen, Y.; Hunstad, D.A.; Wooley, K.L.; Elsabahy, M. Morphologic design of nanostructures for enhanced antimicrobial activity. J. Nanobiotechnol. 2022, 20, 536. [Google Scholar] [CrossRef] [PubMed]
- Arya, A.; Tyagi, P.K.; Bhatnagar, S.; Bachheti, R.K.; Bachheti, A.; Ghorbanpour, M. Biosynthesis and assessment of antibacterial and antioxidant activities of silver nanoparticles utilizing Cassia occidentalis L. seed. Sci. Rep. 2024, 14, 7243. [Google Scholar] [CrossRef] [PubMed]
- Yılmaz, Ç.; Özcengiz, G. Antibiotics: Pharmacokinetics, toxicity, resistance and multidrug efflux pumps. Biochem. Pharmacol. 2017, 133, 43–62. [Google Scholar] [CrossRef] [PubMed]
- CLSI. M100 Performance Standards for Antimicrobial Susceptibility Testing, 33rd ed.; M100ED33; Clinical and Laboratory Standards Institute: Wayne, PA, USA, 2023. [Google Scholar]
- Nazzaro, F.; Fratianni, F.; De Martino, L.; Coppola, R.; De Feo, V. Effect of Essential Oils on Pathogenic Bacteria. Pharmaceuticals 2013, 6, 1451–1474. [Google Scholar] [CrossRef]
- Iseppi, R.; Tardugno, R.; Brighenti, V.; Benvenuti, S.; Sabia, C.; Pellati, F.; Messi, P. Phytochemical Composition and In Vitro Antimicrobial Activity of Essential oils from the Lamiaceae Family against Streptococcus agalactiae and Candida albicans Biofilms. Antibiotics 2020, 9, 592. [Google Scholar] [CrossRef]
- Khalid, A.; Ahmad, P.; Alharthi, A.I.; Muhammad, S.; Khandaker, M.U.; Rehman, M.; Faruque, M.R.I.; Din, I.U.; Alotaibi, M.A.; Alzimami, K.; et al. Structural, Optical, and Antibacterial Efficacy of Pure and Zinc-Doped Copper Oxide Against Pathogenic Bacteria. Nanomaterials 2021, 11, 451. [Google Scholar] [CrossRef]
- Famuyide, I.M.; Aro, A.O.; Fasina, F.O.; Eloff, J.N.; McGaw, L.J. Antibacterial and antibiofilm activity of acetone leaf extracts of nine under-investigated south African Eugenia and Syzygium (Myrtaceae) species and their selectivity indices. BMC Complement. Altern. Med. 2019, 19, 141. [Google Scholar] [CrossRef]
- Aires, A.; Barreto, A.S.; Semedo-Lemsaddek, T. Antimicrobial Effects of Essential Oils on Oral Microbiota Biofilms: The Toothbrush In Vitro Model. Antibiotics 2020, 10, 21. [Google Scholar] [CrossRef]
- Bedlovičová, Z.; Strapáč, I.; Baláž, M.; Salayová, A. A Brief Overview on Antioxidant Activity Determination of Silver Nanoparticles. Molecules 2020, 25, 3191. [Google Scholar] [CrossRef]
- Siddique, M.A.B.; Imran, M.; Haider, A.; Shahzadi, A.; Ul-Hamid, A.; Nabgan, W.; Batool, M.; Khan, K.; Ikram, M.; Somaily, H.H.; et al. Enhancing catalytic and antibacterial activity with size-controlled yttrium and graphene quantum dots doped MgO nanostructures: A molecular docking analysis. Mater. Today Sustain. 2024, 25, 100690. [Google Scholar] [CrossRef]
- Ikram, M.; Shujah, T.; Shahzadi, A.; Haider, A.; Rafique, A.; Ul-Hamid, A.; Nabgan, W.; Haider, S.K.; Alshahrani, T.; Algaradah, M.M.; et al. Multiple phases of yttrium-doped molybdenum trioxide nanorods as efficient dye degrader and bactericidal agents with molecular docking analysis. Chemosphere 2023, 340, 139855. [Google Scholar] [CrossRef] [PubMed]

| Elements | Atomic Percentage |
|---|---|
| Ag-3d | 5.96 |
| O-1s | 70.27 |
| Gd-4d | 3.38 |
| Cr-2p3 | 3.15 |
| N-1s | 13.06 |
| Cl-2p | 4.17 |
| Sample | M20kOe (emu/g) | Ms (emu/g) | Mr × 10−3 (emu/g) | Hci (G) | S |
|---|---|---|---|---|---|
| Doped AgNPs | 0.761 | 0.836 | 51.943 | 156.780 | 0.006 |
| Bacterial Isolates | MICs and MBCs of the Doped AgNPs | |||||
|---|---|---|---|---|---|---|
| Doped AgNPs (mg/mL) | Dox (µg/mL) | |||||
| MIC | MBC | MBC/MIC | MIC | MBC | MBC/MIC | |
| S. aureus | 0.25 | 0.5 | 2 | ND | 1.25 | ND |
| S. haemolyticus | 0.25 | 0.5 | 2 | ND | 1.25 | ND |
| E. faecalis | 1 | >1 | 1 | ND | 1.25 | ND |
| E. coli | 0.125 | 0.25 | 2 | ND | 1.25 | ND |
| K. pneumonia | 0.5 | >1 | 0.5 | ND | 1.25 | ND |
| P. aeruginosa | 0.25 | 0.5 | 2 | ND | 1.25 | ND |
| NPs | Bacterial Isolates | ||||||
|---|---|---|---|---|---|---|---|
| Gram-Positive | Gram-Negative | ||||||
| S. aureus | S. haemolyticus | E. faecalis | E. coli | K. pneumonia | P. aeruginosa | ||
| Sample | Concentration | ZOI ± SEM (mm) | |||||
| Doped AgNPs (mg/mL) | 0.0625 p-value Significance | 7.3 ± 0.27 ˂0.001 *** | 8.0 ± 0.00 0.002 ** | 7.0 ± 0.00 ˂0.001 *** | 0.0 ± 0.00 0.001 *** | 0.0 ± 0.00 ˂0.001 *** | 9.3 ± 0.27 0.003 ** |
| 0.125 p-value Significance | 8.3 ± 0.27 ˂0.001 *** | 8.0 ± 0.00 0.002 ** | 7.3 ± 0.27 ˂0.001 *** | 0.0 ± 0.00 0.001 *** | 7.0 ± 0.00 0.001 *** | 9.3 ± 0.27 0.003 ** | |
| 0.25 p-value Significance | 9.3 ± 0.27 0.001 *** | 8.3 ± 0.27 ˂0.001 *** | 8.0 ± 0.00 ˂0.001 *** | 8.0 ± 0.00 0.003 ** | 7.3 ± 0.27 ˂0.001 *** | 10.3 ± 0.00 0.005 ** | |
| 0.5 p-value Significance | 11.3 ± 0.27 0.001 *** | 8.3 ± 0.27 ˂0.001 *** | 10.3 ± 0.27 ˂0.001 *** | 8.3 ± 0.27 0.001 *** | 7.3 ± 0.27 ˂0.001 *** | 11.0 ± 0.00 0.02 * | |
| 1 p-value Significance | 12.0 ± 0.00 0.006 ** | 8.3 ± 0.27 ˂0.001 *** | 12.0 ± 0.00 0.001 *** | 8.3 ± 0.27 0.001 *** | 8.3 ± 0.27 ˂0.001 *** | 12.0 ± 0.00 0.03 * | |
| Dox (µg/mL) | 1.25 p-value Significance | 19.0 ± 0.47 ˂0.001 *** | 20.0 ± 0.47 ˂0.001 *** | 30 ± 0.47 ˂0.001 *** | 18 ± 0.47 ˂0.001 *** | 20 ± 0.47 ˂0.001 *** | 15 ± 0.47 ˂0.001 *** |
| Bacterial Isolates | Time of Inhibition of Bacterial Growth (h) | |
|---|---|---|
| Doped AgNPs | Dox | |
| S. aureus | 3 | 2 |
| S. haemolyticus | 3 | 2 |
| E. faecalis | 3 | 2 |
| E. coli | 3 | 2 |
| K. pneumonia | 3 | 2 |
| P. aeruginosa | 3 | 2 |
| Bacteria | 3D Structure | Hydrophilic Interactions | Hydrophobic Contacts | No. of H-Bonds | No. of Total Bonds | Affinity kcal mol−1 | |||
|---|---|---|---|---|---|---|---|---|---|
| Residue (H-Bond) | Length | Residue (Bond Type) | Length | ||||||
| 1 | E. coli | ![]() | Ser73 (H-Bond) Glu42 (H-Bond) | 2.33 2.55 | Glu42 (Metal–Acceptor) Met166 (Metal–Acceptor) Ser70 (Metal–Acceptor) Asp73 (Metal–Acceptor) Glu42 (Metal–Acceptor) Gln143 (Metal–Acceptor) Phe169 (Pi–Sigma) | 2.62 2.09 3.21 2.36 1.18 2.95 3.90 | 2 | 9 | −9.80 |
| 2 | E. faecalis | ![]() | Ile516 (H-Bond) Thr519 (H-Bond) Ile547 (H-Bond) | 3.22 261 3.00 | Ser367 (C-H-Bond) Thr651 (Metal–Acceptor) Gln551 (Metal–Acceptor) Ser367 (Metal–Acceptor) Tyr420 (Metal–Acceptor) Thr418 (Metal–Acceptor) Val369 (Metal–Acceptor) Leu650 (Metal–Acceptor) Ile550 (Metal–Acceptor) Val382, (Metal–Acceptor) | 2.11 3.10 4.25 1.95 2.44 3.15 4.80 2.11 2.00 3.50 | 3 | 13 | −10.22 |
| 3 | K. pneumonia | ![]() | - | - | Leu148 (Metal–Acceptor) Met152 (Metal–Acceptor) Tyr247(Metal–Acceptor) Thr235 (Metal–Acceptor) Gly232 (Metal–Acceptor) Arg161 (Metal–Acceptor) Thr180 (Metal–Acceptor) Asp157 (Metal–Acceptor) Phe66 (Metal–Acceptor) | 3.26 3.34 2.87 2.11 2.85 2.90 3.12 2.54 3.26 | 0 | 9 | −10.20 |
| 4 | P. aeruginosa | ![]() | Lys34 (H-Bond) Gly126 (H-Bond) | 2.11 3.22 | Phe51 (Metal–Acceptor) Gly38 (Metal–Acceptor) Ser129 (Metal–Acceptor) Lys34 (Metal–Acceptor) Gly126 (Metal–Acceptor) Pro117 (Metal–Acceptor) | 2.23 1.30 2.11 1.79 2.48 3.08 | 2 | 8 | −11.90 |
| 5 | S. aureus | ![]() | - | - | Ile170 (Metal–Acceptor) Val49 (Metal–Acceptor) Leu197 (Metal–Acceptor) Gln105 (Metal–Acceptor) Thr200 (Metal–Acceptor) Thr227 (Metal–Acceptor) Arg239 (Metal–Acceptor) Leu198 (Metal–Acceptor) Asp45 (Metal–Acceptor) Ala237 (Metal–Acceptor) Val49 (Metal–Acceptor) Val196 (Metal–Acceptor) | 3.30 2.77 1.30 2.75 2.86 3.32 2.12 1.65 3.36 1.52 3.39 2.91 | 0 | 12 | −11.00 |
| 6 | S. haemolyticus | ![]() | Asp46 (H-Bond) Leu89 (H-Bond) | 2.33 1.90 | Gly29 (C-H bond) Asp90 (Metal–Acceptor) Asp48 (Metal–Acceptor) Asp46 (Metal–Acceptor) Trp26 (Metal–Acceptor) Asp153 (Metal–Acceptor) Asp46 (Metal–Acceptor) Ile91 (Metal–Acceptor) Leu89 (Metal–Acceptor) | 2.22 2.20 2.01 1.98 1.56 2.91 3.01 1.54 3.26 | 2 | 11 | −9.50 |
Disclaimer/Publisher’s Note: The statements, opinions and data contained in all publications are solely those of the individual author(s) and contributor(s) and not of MDPI and/or the editor(s). MDPI and/or the editor(s) disclaim responsibility for any injury to people or property resulting from any ideas, methods, instructions or products referred to in the content. |
© 2024 by the authors. Licensee MDPI, Basel, Switzerland. This article is an open access article distributed under the terms and conditions of the Creative Commons Attribution (CC BY) license (https://creativecommons.org/licenses/by/4.0/).
Share and Cite
Darwich, N.A.; Mezher, M.; Abdallah, A.M.; El-Sayed, A.F.; El Hajj, R.; Hamdalla, T.A.; Khalil, M.I. Biosynthesis; Characterization; and Antibacterial, Antioxidant, and Docking Potentials of Doped Silver Nanoparticles Synthesized from Pine Needle Leaf Extract. Processes 2024, 12, 2590. https://doi.org/10.3390/pr12112590
Darwich NA, Mezher M, Abdallah AM, El-Sayed AF, El Hajj R, Hamdalla TA, Khalil MI. Biosynthesis; Characterization; and Antibacterial, Antioxidant, and Docking Potentials of Doped Silver Nanoparticles Synthesized from Pine Needle Leaf Extract. Processes. 2024; 12(11):2590. https://doi.org/10.3390/pr12112590
Chicago/Turabian StyleDarwich, Nourhane A., Malak Mezher, Alaa M. Abdallah, Ahmed F. El-Sayed, Rana El Hajj, Taymour A. Hamdalla, and Mahmoud I. Khalil. 2024. "Biosynthesis; Characterization; and Antibacterial, Antioxidant, and Docking Potentials of Doped Silver Nanoparticles Synthesized from Pine Needle Leaf Extract" Processes 12, no. 11: 2590. https://doi.org/10.3390/pr12112590
APA StyleDarwich, N. A., Mezher, M., Abdallah, A. M., El-Sayed, A. F., El Hajj, R., Hamdalla, T. A., & Khalil, M. I. (2024). Biosynthesis; Characterization; and Antibacterial, Antioxidant, and Docking Potentials of Doped Silver Nanoparticles Synthesized from Pine Needle Leaf Extract. Processes, 12(11), 2590. https://doi.org/10.3390/pr12112590







